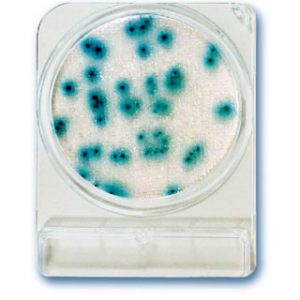

Contacts
Our company is located in the most beautiful nature in Bavaria and yet in the immediate vicinity of the important logistics center of Munich. This location advantage and our flat hierarchies enable us to do something we are particularly proud of: our extremely short delivery times. Contact us!
- Tel.: +49 (0) 89 3703 1223
- Fax: +49 (0) 89 3703 1225
- E-Mail: info@hyserve.com